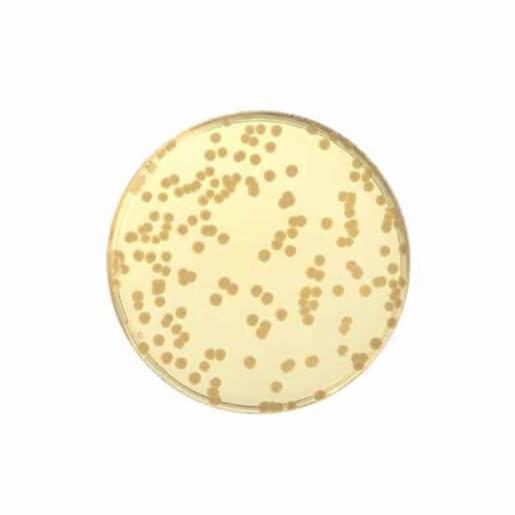
Biokar Trypto-casein Soy Agar (TSA) - Ready-to-melt medium 10 vials 100 mL BM01708

Biokar Trypto-casein Soy Agar (TSA) - Ready-to-melt medium 10 vials 100 mL BM01708
Introducing the Biokar Trypto-casein Soy Agar (TSA) - Ready-to-melt medium 10 vials 100 mL BM01708 from Biokar. This general-purpose culture medium is designed for the isolation and cultivation of microorganisms in clinical and environmental samples.
Benefits/Advantages:
• Convenient and time-saving: The ready-to-melt format eliminates the need for preparation and sterilization, saving valuable time and effort.
• High-quality ingredients: Made with high-quality ingredients, ensuring optimal growth and recovery of microorganisms.
• Sterility: Gamma irradiation is used to sterilize the medium, ensuring its purity and preventing contamination.
• Versatile applications: Suitable for clinical, environmental, and food microbiology applications.
• ISO 11133:2014 compliant: Manufactured according to international quality standards for reliable and consistent performance.
Experience the convenience and reliability of Biokar Trypto-casein Soy Agar (TSA) - Ready-to-melt medium for your microbial culture needs. Trust in Biokar's expertise and quality in providing innovative solutions to the microbiology field.
Product Details
Overview
| Model | |
|---|---|
| Product Type | Consumables |
| Part Number | BM01708 |
| Brand | Biokar |
| Gross Dimensions (WxDxH cm) | |
| Net Dimensions (WxDxH cm) | |
| Gross Weight (kg) | |
| Net Weight (kg) |
Specifications
| Format | Ready To Use |
|---|---|
| PackingSize | 10vial |
Videos
Biokar
Biokar Diagnostics is the microbiology division of the Solabia group, dedicated to the development, production and selling of culture media, supplements and detection kits for microbiology laboratories.
With over 300 products and a presence in over 40 countries, Biokar Diagnostics has acquired an international reputation for the quality of his products and innovative solutions.